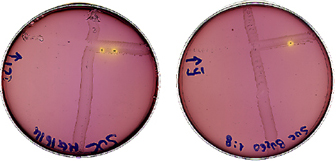

7. Miglioramento
genetico
dei microrganismi
L'esperienza insegna che in natura
esistono microrganismi con proprietà straordinarie.
Con intelligenza e fortuna possono essere isolati, selezionati ed
utilizzati per le applicazioni più disparate.
Tuttavia oggi si dispone di
tecniche per modificare in laboratorio le caratteristiche dei sistemi
biologici.
Pertanto, da ceppi "wild", cioè selvaggi, si può
giungere a ceppi più interessanti.
La figura successiva mostra le metodologie che consentono di modificare le caratteristiche dei microrganismi.

L'ottenimento di mutanti più interessanti rappresenta sicuramente una buona prospettiva.
Di seguito sono ricordati gli agenti ed i trattamenti mutageni; quindi le conseguenze a livello molecolare.


Eventi ricombinazionali legati a processi naturali, quali la coniugazione, possono ugualmente portare a modificazioni.
L'immagine che segue mostra lattococchi transconiuganti resistenti alla Rifampicina ed alla Streptomicina che hanno acquisito la capacità di fermentare il Saccarosio grazie al contatto su piastra con cellule di lattococchi non resistenti ai due antibiotici, ma recanti un trasposone coniugativo provvisto del gene Suc.
L'ingegneria genetica ricorre in larga misura alla "clonazione" dei geni.
Di seguito è specificato il significato della clonazione.

L'obiettivo della clonazione di un gene può essere conseguito adottando strategie diverse, dipendenti dalle circostanze di ricerca.
Nella figura che segue sono riportati i casi fondamentali.

Nell'ambito dei primi due casi riveste un ruolo essenziale la tecnica che sfrutta la Polymerase Chain Reaction (PCR).
La figura che segue schematizza la PCR. La successiva è riferita alla cinetica della produzione degli ampliconi.


I vettori di clonazione sono entità genetiche che consentono di introdurre il gene clonato in cellule che, moltiplicandosi, possono produrne più copie.
La diapositiva che segue riporta i requisiti di un vettore di clonazione. La successiva ricorda la natura dei diversi vettori utilizzabili.


Particolari tipi di vettori, e relative proprietà ed applicazioni, sono ricordati di seguito.

Nell'ambito del terzo tipo di strategia è essenziale l'impiego delle endonucleasi di restrizione.
In realtà questi enzimi, spesso paragonati a "bisturi" di precisione utilizzati nella "chirurgia" del DNA ricorrente nell'ingegneria genetica, sono indispensabili in tutte letecniche di clonazione.
La figura che segue riporta alcune endonucleasi, diverse per sito e modalità di "taglio".

Di particolare utilità sono
le endonucleasi che eseguono tagli asimmetrici, producendo frammenti
di DNA con estremità non completamente appaiate, dette
"appiccicose".
Questi frammenti possono essere facilmente incorporati in vettori,
molecole "ccc", contenenti un solo sito specifico di taglio e quindi
linearizzabili con lo stesso enzima di restrizione.
La figura che segue è relativa a questo processo.

La figura successiva illustra l'impiego del colifago Lambda come vettore di clonazione. In questo caso, i geni eterologhi sostituiscono quelli non indispensabili alla biologia del batteriofago fago.

Le molecole ricombinanti (vettori recanti frammenti di DNA eterologo) vengono introdotte in una popolazione di cellule: ciò può essere fatto per "elettroporazione", se non è stato utilizzato un batteriofago come vettore.
Viene poi il momento di individuare le cellule trasformate col frammento di DNA giusto, cioè contenente il gene target.
Nelle figure successive sono richiamate le procedure che possono essere seguite per il riconoscimento dei "costrutti" recanti il gene target.


La Biologia molecolare e le biotecnologie del DNA ricombinante hanno prospettato e consentito diverse nuove applicazioni della Microbiologia.
A conclusione di questa parte del Corso di Microbiologia generale lo schema che segue ricorda le principali procedure che afferiscono alle biotecnologie microbiche. Quella successiva riporta il percorso applicato a un ceppo di Bacillus subtilis migliorato geneticamente per la produzione di alfa-amilasi.

Lo schema evidenzia come il
miglioramento genetico di un microrganismo di interesse industriale
si consegue in realtà attraverso strategie complesse che
possono coinvolgere materiale biologico di diversa origine e
metodologie differenti.
Nell'esempio mostrato, i diversi ceppi di
Bacillus
subtilis sono indicati nei
riquadri; la produttività di ogni ceppo è riportata al
di sopra di ciascun riquadro; la tecnica di miglioramento è
indicata vicino alle frecce, come
tf,
per la trasformazione, o come
NTG,
per la mutazione con nitrosoguanidina. Il miglioramento genetico, che
ha portato al ceppo T2N26, producente 16.000 volte la quantità
di alfa-amilasi prodotta dal ceppo
wild
type, si è servito di
tre ceppi selezionati: il 6160, il ceppo Natto ed il ceppo Sac,
producenti, rispettivamente, 10, 40 e 130 volte rispetto al
wild
type.
Torna all'indice
della
GuidaVai alla parte
ottava